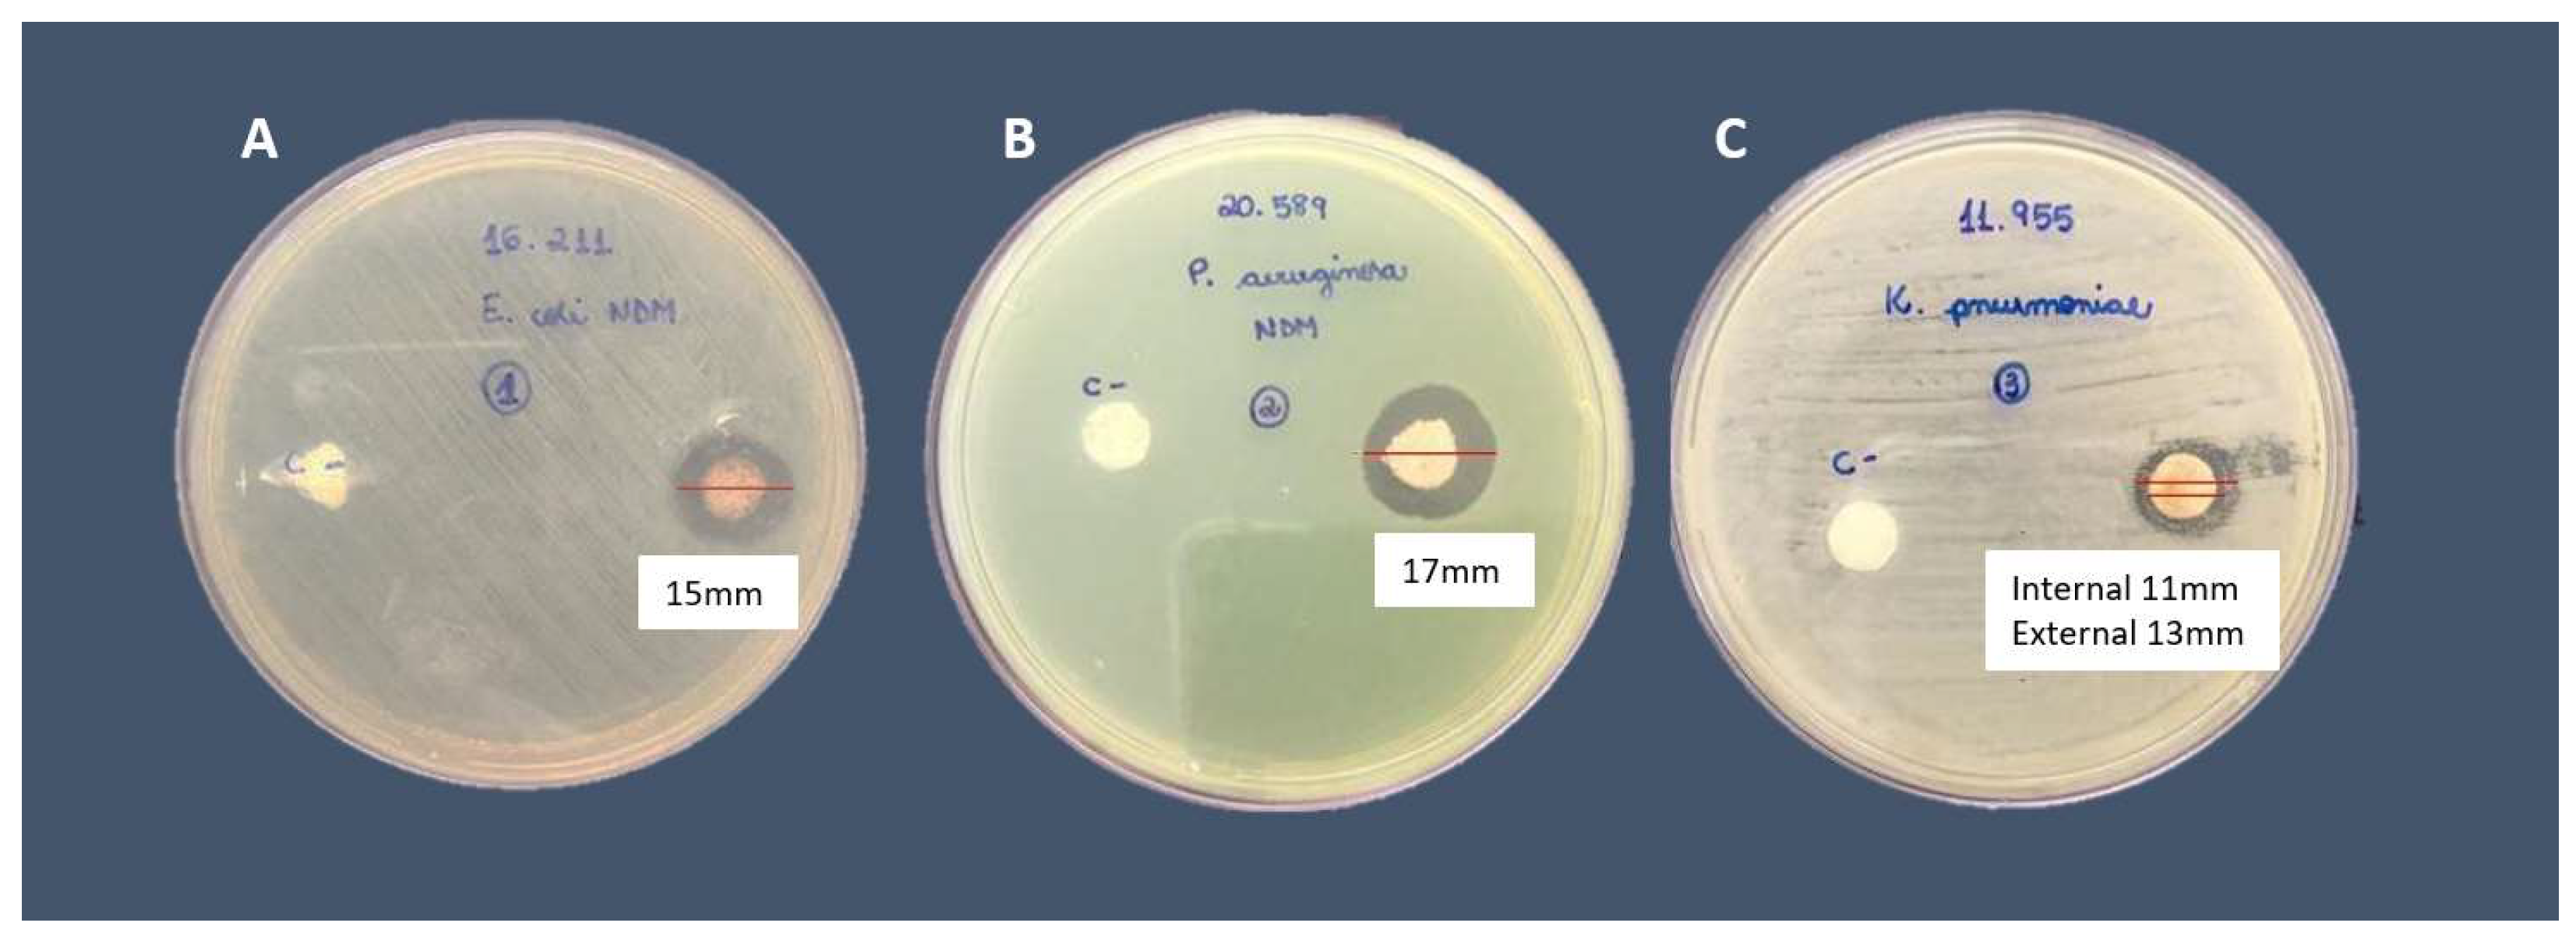
Compounds 03 00042 g006

Antimicrobial Activity of Bovine Bone Scaffolds Impregnated with Silver Nanoparticles on New Delhi Metallo-β-Lactamase-Producing Gram-Negative Bacilli Biofilms
Abstract
:1. Introduction
2. Materials and Methods
2.1. Bone Scaffolds’ Processing, Nanoparticles’ Synthesis, and AgNPs’ Impregnation
2.2. Qualitative Bone Disc Scaffold Analysis through Scanning Electronic Microscopy and Energy-Dispersion X-ray Spectroscopy
2.3. Microorganisms, Silver Nitrate Minimum Inhibitory Concentration (MIC) and Minimal Bactericidal Concentration (MBC), Disc-Diffusion Tests for AgNPs Susceptibility, and Biofilm Production and Evaluation on Bone
3. Results
4. Discussion
5. Conclusions
Author Contributions
Funding
Institutional Review Board Statement
Informed Consent Statement
Data Availability Statement
Acknowledgments
Conflicts of Interest
References
- Galia, C.R.; Junior, G.D.L.; Ávila, L.M.; Rosito, R.; Macedo, C.A.S. Enxerto bovino liofilizado: Comportamento histológico após seguimento de 49 meses em seres humanos. Rev. Bras. Ortop. 2012, 47, 770–775. [Google Scholar] [CrossRef]
- Sugihara, S.; Van Ginkel, A.D.; Jiya, T.U.; Van Royen, B.J.; Van Diest, P.J.; Wuisman, P.I.J.M. Histopathology of retrieved allografts of the femoral head. J. Bone Jt. Surg. B 1999, 81, 336–341. [Google Scholar] [CrossRef]
- Saikia, K.C.; Bhattacharya, T.D.; Bhuyan, S.K.; Talukdar, D.J.; Saikia, S.P.; Jitesh, P. Calcium phosphate ceramics as bone graft substitutes in filling bone tumor defects. Indian J. Orthop. 2008, 42, 169. [Google Scholar] [CrossRef]
- Oliveira, R.; Sicca, C.; Silva, T. Da Temperatura De Desproteinização No Preparo De Osso Cortical Bovino Microgranular: Avaliação Microscópica E Bioquímica Da Resposta Celular Em Subcutâneo De. Rev. Fac. Odontol. 1999, 7, 85–93. [Google Scholar]
- Iviglia, G.; Kargozar, S.; Baino, F. Biomaterials, Current Strategies, and Novel Nano-Technological Approaches for Periodontal Regeneration. Funct. Biomater. 2019, 10, 3. [Google Scholar] [CrossRef]
- Del Pozo, J.L.; Patel, R. Clinical practice. Infection associated with prosthetic joints. N. Engl. J. Med. 2009, 361, 787–794. [Google Scholar] [CrossRef]
- Frommelt, T.L. Principles of systemic antimicrobial therapy in foreign material associated infection in bone tissue, with special focus on periprosthetic infection. Injury 2006, 37, S87–S94. [Google Scholar] [CrossRef]
- Zimmerli, W. Infection and musculoskeletal conditions: Prosthetic-joint-associated infections. Best Pract. Res. Clin. Rheumatol. 2006, 20, 1045–1063. [Google Scholar] [CrossRef]
- Nordmann, P.; Poirel, L.; Walsh, T.R.; Livermore, D.M. The emerging NDM carbapenemases. Trends Microbiol. 2011, 19, 588–595. [Google Scholar] [CrossRef]
- Hansen, G.T. Continuous Evolution: Perspective on the Epidemiology of Carbapenemase Resistance Among Enterobacterales and Other Gram-Negative Bacteria. Infect. Dis. Ther. 2021, 10, 75–92. [Google Scholar] [CrossRef]
- Tuon, F.F.; Rocha, J.L.; Gasparetto, J. Polymyxin B and colistin-the economic burden of nephrotoxicity against multidrug resistant bacteria. J. Med. Econ. 2019, 22, 158–162. [Google Scholar] [CrossRef]
- Allaker, R.P. The use of nanoparticles to control oral biofilm formation. J. Dent. Res. 2010, 89, 1175–1186. [Google Scholar] [CrossRef] [PubMed]
- Tian, J.; Wong, K.K.; Ho, C.M.; Lok, C.N.; Yu, W.Y.; Che, C.M.; Cliu, J.F.; Tam, P.K. Topical delivery of silver nanoparticles promotes wound healing. Chem. Med. Chem. 2007, 2, 129–136. [Google Scholar] [CrossRef] [PubMed]
- Kose, N.; Asfuroglu, Z.M.; Kose, A.; Şahintürk, V.; Gürbüz, M.; Doğan, A. Silver ion-doped calcium phosphate-based bone-graft substitute eliminates chronic osteomyelitis: An experimental study in animals. J. Orthop. Res. 2021, 39, 1390–1401. [Google Scholar] [CrossRef] [PubMed]
- Qureshi, R.; Qamar, M.U.; Shafique, M.; Muzammil, S.; Rasool, M.H.; Ahmad, I.; Ejaz, H. Antibacterial efficacy of silver nanoparticles against metallo-beta-lactamase (blaNDM, blaVIM, blaOXA) producing clinically isolated Pseudomonas aeruginosa. Pak. J. Pharm. Sci. 2021, 34, 237–243. [Google Scholar] [PubMed]
- Dantas, L.R.; Wollmann, L.C.; Suss, P.H.; Kraft, L.; Ribeiro, V.S.T.; Tuon, F.F. Disinfection protocol for human musculoskeletal allografts in tissue banking using hydrogen peroxide 30. Cell Tissue Bank. 2021, 22, 643–649. [Google Scholar] [CrossRef]
- Dong, H.; Dong, W.; Sun, G.; Hinestroza, J. Assembly of Metal Nanoparticles on Electrospun Nylon 6 Nanofibers by Control of Interfacial Hydrogen-Bonding Interactions. Chem. Mater. 2015, 20, 5. [Google Scholar] [CrossRef]
- Paramelle, D.; Sadovoy, A.; Gorelik, S.; Free, P.; Hobley, J.; Ferning, D.G. A rapid method to estimate the concentration of citrate capped silver nanoparticles from UV-visible light spectra. Analyst 2014, 139, 4855–4861. [Google Scholar] [CrossRef]
- Becerril-Juáres, I.G.; Morales-Luckie, R.A.; Ureña-Nuñez, F.; Arenas-Alatorre, J.A.; Hinestroza, J.P.; Sánchez-Mendieta, V. Silver micro-, submicro- and nano-crystals using bovine bone as template. Formation of a silver/bovine bone composite. Mat. Lett. 2012, 85, 4. [Google Scholar] [CrossRef]
- Sutterlin, S.; Tano, E.; Bergsten, A.; Tallberg, A.B.; Melhus, A. Effects of silver-based wound dressings on the bacterial flora in chronic leg ulcers and its susceptibility in vitro to silver. Acta Derm. Venereol. 2012, 92, 34–39. [Google Scholar] [CrossRef]
- CLSI DOCUMENT M07-A10; Methods for Dilution Antimicrobial Susceptibility Tests for Bacteria that Grow Aerobically. Approved Standard-Tenth Edition. Clinical and Laboratory Standards Institute: Malvern, PA, USA, 2015.
- Saegeman, V.; Ectors, N.; Lismont, D.; Verduyckt, B.; Verhaegen, J. Bacteriostasis testing on allograft tissue inoculated in Wilkins-Chalgren broth. J. Hosp. Infect. 2008, 70, 278–283. [Google Scholar] [CrossRef] [PubMed]
- Pollini, M.; Paladini, F.; Catalano, M.; Taurino, A.; Licciulli, A.; Maffezzoli, A.; Sannino, A. Antibacterial coatings on haemodialysis catheters by photochemical deposition of silver nanoparticles. J. Mat. Sci. Mat. Med. 2011, 22, 2005–2012. [Google Scholar] [CrossRef] [PubMed]
- Franklin, M.J.; Chang, C.; Akiyama, T.; Bothner, B. New Technologies for Studying Biofilms. Microbiol. Spectr. 2015, 3, MB0016-2014. [Google Scholar] [CrossRef] [PubMed]
- Cieslinki, J.; Ribeiro, V.S.T.; Kraft, L.; Suss, P.H.; Rosa, E.; Morello, L.G.M.; Pillonetto, M.; Tuon, F.F. Direct detection of microorganisms in sonicated orthopedic devices after in vitro biofilm production and different processing conditions. Eur. J. Orthop. Surg. Traumatol. 2021, 31, 1113–1120. [Google Scholar] [CrossRef]
- Trampuz, A.; Piper, K.E.; Jacobson, M.J.; Hanssen, A.D.; Uni, K.K.; Osmon, D.R.; Mandrekar, J.N.; Cockerill, F.R.; Steckelberg, J.M.; Greenleaf, J.F.; et al. Sonication of removed hip and knee prostheses for diagnosis of infection. N. Engl. J. Med. 2007, 357, 654–663. [Google Scholar] [CrossRef] [PubMed]
- Davido, B.; Noussair, L.; Saleh-Mghir, A.; Salomon, E.; Bouchand, F.; Matt, M.; Lawrence, C.; Bauer, T.; Herrmann, J.; Perronne, C.; et al. Case series of carbapenemase-producing Enterobacteriaceae osteomyelitis: Feel it in your bones. J. Glob. Antimicrob. Resist. 2020, 23, 74–78. [Google Scholar] [CrossRef]
- Buckley, J.J.; Lee, A.F.; Olivic, L.; Wilsonb, K. Hydroxyapatite supported antibacterial Ag3PO4 nanoparticles. J. Mater. Chem. 2010, 20, 8056–8063. [Google Scholar] [CrossRef]
- Ciobanu, C.S.; Massuyeau, F.; Constantin, L.V.; Predoi, D. Structural and physical properties of antibacterial Ag-doped nano-hydroxyapatite synthesized at 100 °C. Nanoscale Res. Lett. 2011, 6, 613. [Google Scholar] [CrossRef]
- Hotta, M.; Nakajima, H.; Yamamoto, K.; Aono, M. Antibacterial temporary filling materials: The effect of adding various ratios of Ag-Zn-Zeolite. J. Oral. Rehabil. 1998, 25, 485–489. [Google Scholar] [CrossRef]
- Kvítek, L.; Panáćek, A.; Soukupová, J.; Kolář, M.; Večeřová, R.; Prucek, R.; Holecová, M.; Zbořil, R. Effect of surfactants and polymers on stability and antibacterial activity of silver nanoparticles (NPs). J. Phys. Chem. C 2008, 112, 5825–5834. [Google Scholar] [CrossRef]
- John, M.S.; Nagoth, J.A.; Ramasamy, K.P.; Ballarini, P.; Mozzicafreddo, M.; Mancini, A.; Telatin, A.; Liò, P.; Giuli, G.; Natalello, A.; et al. Horizontal gene transfer and silver nanoparticles production in a new Marinomonas strain isolated from the Antarctic psychrophilic ciliate Euplotes focardii. Sci. Rep. 2020, 10, 10218. [Google Scholar] [CrossRef] [PubMed]
- Mathur, P.; Jha, S.; Ramteke, S.; Jain, N.K. Pharmaceutical aspects of silver nanoparticles. Artif. Cells Nanomed. Biotechnol. 2018, 46, 115–126. [Google Scholar] [CrossRef]
- Bhatia, E.; Banerjee, R. Hybrid silver-gold nanoparticles suppress drug resistant polymicrobial biofilm formation and intracellular infection. J. Mater. Chem. B 2020, 8, 4890–4898. [Google Scholar] [CrossRef] [PubMed]
- Mih, N.; Monk, J.M.; Fang, X.; Catoiu, E.; Heckman, D.; Yang, L.; Palsson, B.O. Adaptations of Escherichia coli strains to oxidative stress are reflected in properties of their structural proteomes. BMC Bioinform. 2020, 21, 162. [Google Scholar] [CrossRef]
- Baker, C.; Pradhan, A.; Pakstis, L.; Pochan, D.J.; Shah, S.I. Synthesis and antibacterial properties of silver nanoparticles. J. Nanosci. Nanotechnol. 2005, 5, 244–249. [Google Scholar] [CrossRef]
- Stoodley, P.; deBeer, D.; Lappin-Scott, H.M. Influence of electric fields and pH on biofilm structure as related to the bioelectric effect. Antimicrob. Agents Chemother. 1997, 41, 1876–1879. [Google Scholar] [CrossRef]
- Scandorieiro, S.; Teixeira, F.M.M.B.; Nogueira, M.C.L.; Panagio, L.A.; de Oliveira, A.G.; Durán, N.; Nakazato, G.; Kobayashi, R.K.T. Antibiofilm Effect of Biogenic Silver Nanoparticles Combined with Oregano Derivatives against Carbapenem-Resistant Klebsiella pneumoniae. Antibiotics 2023, 14, 756. [Google Scholar] [CrossRef]
- Martinez, L.C.; Vadyvaloo, V. Mechanisms of post-transcriptional gene regulation in bacterial biofilms. Front. Cell. Infect. Microbiol. 2014, 4, 38. [Google Scholar] [CrossRef]
- Olson, M.E.; Ceri, H.; Morck, D.W.; Buret, A.G.; Read, R.R. Biofilm bacteria: Formation and comparative susceptibility to antibiotics. Can. J. Vet. Res. 2002, 66, 86–92. [Google Scholar]
- Zhang, Y.; Pan, X.; Liao, S.; Jiang, C.; Wang, L.; Tang, Y. Quantitative Proteomics Reveals the Mechanism of Silver Nanoparticles against Multidrug-Resistant Pseudomonas aeruginosa Biofilms. J. Proteome Res. 2020, 19, 3109–3122. [Google Scholar] [CrossRef]
- Anuj, S.A.; Gajera, H.P.; Hirpara, D.G.; Golakiya, B.A. Bacterial membrane destabilization with cationic particles of nano-silver to combat efflux-mediated antibiotic resistance in Gram-negative bacteria. Life Sci. 2019, 230, 178–187. [Google Scholar] [CrossRef] [PubMed]
- Saeki, E.K.; Martins, H.M.; Camargo, L.C.; Anversa, L.; Tavares, E.R.; Yamada-Ogatta, S.F.; Lioni, L.M.Y.; Kobayashi, R.K.T.; Nakazato, G. Effect of Biogenic Silver Nanoparticles on the Quorum-Sensing System of Pseudomonas aeruginosa PAO1 and PA14. Microorganisms 2022, 30, 1755. [Google Scholar] [CrossRef] [PubMed]
- Qais, F.A.; Shafiq, A.; Ahmad, I.; Husain, F.M.; Khan, R.A.; Hassan, I. Green synthesis of silver nanoparticles using Carum copticum: Assessment of its quorum sensing and biofilm inhibitory potential against gram negative bacterial pathogens. Microb. Pathog. 2020, 144, 104172. [Google Scholar] [CrossRef] [PubMed]
- Agnihotri, S.; Mukherji, S. Size-controlled silver nanoparticles synthesized over the range 5-100 nm using the same protocol and their antibacterial efficacy. RSC Adv. 2014, 4, 3974–3983. [Google Scholar] [CrossRef]
- Mulfinger, L.; Solomon, S.D.; Bahadory, M.; Jeyarajasingam, A.V.; Rutkowsky, S.; Boritz, C. Synthesis and study of silver nanoparticles. J. Chem. Educ. 2007, 84, 322. [Google Scholar] [CrossRef]
- Melo, M.A.; Santos, L.S.S.; Gonçalves, M.D.C.; Nogueira, A.F. Preparation of silver and gold nanoparticles: A simple method to introduce nanotechnology into teaching laboratories. Química Nova 2012, 35, 1872–1878. [Google Scholar]
- Van Hyning, D.L.; Zukoski, C.F. Formation mechanisms and aggregation behavior of borohydride reduced silver particles. Langmuir 1998, 14, 7034–7046. [Google Scholar] [CrossRef]
- Cooney, D.O. Adsorption Design for Wastewater Treatment; CRC Press: Boca Raton, FL, USA, 1998. [Google Scholar]
- Nascimento, R.F.; Melo, D.Q.; Lima, A.C.A.; Barros, A.L.; Vidal, C.B.; Raulino, G.S.C. Equilíbrio de Adsorção. Adsorção Aspectos Teóricos e Aplicações Ambientais; Imprensa Universitária da Universidade Federal do Ceará: Fortaleza, Brazil, 2014. [Google Scholar]
- Foust, A.S. Princípios das Operações Unitárias; Elsevier: Porto Alegre, Brazil, 1982. [Google Scholar]
- Freire, N.B.; Pires, L.C.S.R.; Oliveira, H.P.; Costa, M.M. Antimicrobial and antibiofilm activity of silver nanoparticles against Aeromonas spp. isolated from aquatic organisms. Pesqui. Vet. Bras. 2018, 38, 244–249. [Google Scholar] [CrossRef]
- Nikaido, H. Prevention of drug access to bacterial targets: Permeability barriers and active efflux. Science 1994, 264, 382–388. [Google Scholar] [CrossRef]
- Percival, S.L.; Bowler, P.G.; Russel, D. Bacterial resistance to silver in wound care. J. Hosp. Infect. 2005, 60, 1–7. [Google Scholar] [CrossRef]
- Silver, S.; Phung, L.T. Bacterial heavy metal resistance: New surprises. Annu. Rev. Microbiol. 1996, 50, 753–789. [Google Scholar] [CrossRef] [PubMed]
- Trentin, D.D.S.; Giordani, R.B.; Macedo, A.J. Biofilmes bacterianos patogênicos: Aspectos gerais, importância clínica e estratégias de combate. Rev. Lib. 2013, 14, 22. [Google Scholar]
- Wingender, J.; Neu, T.R.; Fleming, H.C. Microbial Extracellular Polymeric Substances: Characterization, Structure, and Function; Springer: Berlin/Heidelberg, Germany, 1999. [Google Scholar]
- Chaw, K.C.; Manimaran, M.; Tay, F.E.H. Role of silver ions in destabilization of intermolecular adhesion forces measured by atomic force microscopy in Staphylococcus epidermidis biofilms. Antimicrob. Agents Chemother. 2005, 49, 4853–4859. [Google Scholar] [CrossRef] [PubMed]
- Kalishwaralal, K.; BarathManiKanth, S.; Pandian, S.R.K.; Deepak, V.; Gurunathan, S. Silver nanoparticles impede the biofilm formation by Pseudomonas aeruginosa and Staphylococcus epidermidis. Colloids Surf. B Biointerfaces 2010, 79, 340–344. [Google Scholar] [CrossRef]
- Morones, J.R.; Elechiguerra, J.L.; Camacho, A.; Holt, K.; Kouri, J.B.; Ramírez, J.T.; Yacaman, M.J. The bactericidal effect of silver nanoparticles. Nanotechnology 2005, 16, 2346–2353. [Google Scholar] [CrossRef]
- Sondi, I.; Salopek-Sondi, B. Silver nanoparticles as antimicrobial agent: A case study on E. coli as a model for Gram-negative bacteria. J. Colloid Interface Sci. 2004, 275, 177–182. [Google Scholar] [CrossRef]
- Fabrega, J.; Renshaw, J.C.; Lead, J.R. Interactions of silver nanoparticles with Pseudomonas putida biofilms. Environ. Sci. Technol. 2009, 43, 9004–9009. [Google Scholar] [CrossRef]

Disclaimer/Publisher’s Note: The statements, opinions and data contained in all publications are solely those of the individual author(s) and contributor(s) and not of MDPI and/or the editor(s). MDPI and/or the editor(s) disclaim responsibility for any injury to people or property resulting from any ideas, methods, instructions or products referred to in the content. |
© 2023 by the authors. Licensee MDPI, Basel, Switzerland. This article is an open access article distributed under the terms and conditions of the Creative Commons Attribution (CC BY) license (https://creativecommons.org/licenses/by/4.0/).
Share and Cite
Gonçalves, G.A.; Ribeiro, V.S.T.; Dantas, L.R.; de Andrade, A.P.; Suss, P.H.; Witt, M.A.; Tuon, F.F. Antimicrobial Activity of Bovine Bone Scaffolds Impregnated with Silver Nanoparticles on New Delhi Metallo-β-Lactamase-Producing Gram-Negative Bacilli Biofilms. Compounds 2023, 3, 584-595. https://doi.org/10.3390/compounds3040042
Gonçalves GA, Ribeiro VST, Dantas LR, de Andrade AP, Suss PH, Witt MA, Tuon FF. Antimicrobial Activity of Bovine Bone Scaffolds Impregnated with Silver Nanoparticles on New Delhi Metallo-β-Lactamase-Producing Gram-Negative Bacilli Biofilms. Compounds. 2023; 3(4):584-595. https://doi.org/10.3390/compounds3040042
Chicago/Turabian StyleGonçalves, Geiziane Aparecida, Victoria Stadler Tasca Ribeiro, Leticia Ramos Dantas, Ana Paula de Andrade, Paula Hansen Suss, Maria Alice Witt, and Felipe Francisco Tuon. 2023. "Antimicrobial Activity of Bovine Bone Scaffolds Impregnated with Silver Nanoparticles on New Delhi Metallo-β-Lactamase-Producing Gram-Negative Bacilli Biofilms" Compounds 3, no. 4: 584-595. https://doi.org/10.3390/compounds3040042
APA StyleGonçalves, G. A., Ribeiro, V. S. T., Dantas, L. R., de Andrade, A. P., Suss, P. H., Witt, M. A., & Tuon, F. F. (2023). Antimicrobial Activity of Bovine Bone Scaffolds Impregnated with Silver Nanoparticles on New Delhi Metallo-β-Lactamase-Producing Gram-Negative Bacilli Biofilms. Compounds, 3(4), 584-595. https://doi.org/10.3390/compounds3040042

